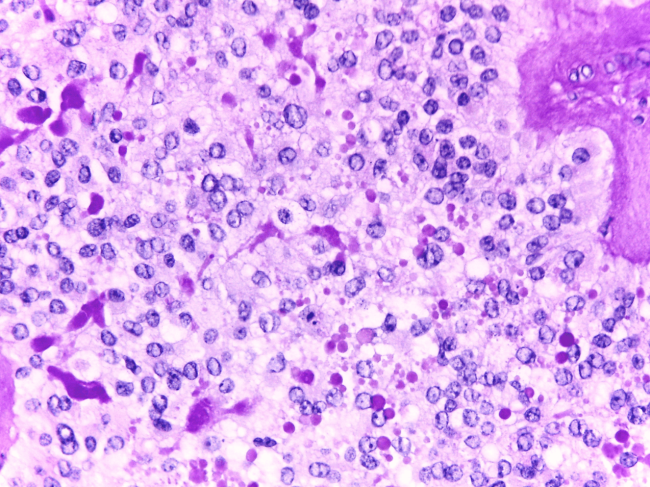

Unidade de Tumores Gastrointestinais
A Unidade de Tumores Gastrointestinais tem como missão o diagnóstico, tratamento e seguimento dos doentes com tumores do sistema digestivo alto como o cancro do estômago, cancro do esófago e também dos tumores hepatobiliopancreáticos como o cancro do pâncreas, cancro do fígado e cancro das vias biliares.
Organização Clínica
Na CUF Oncologia, esta unidade tem uma coordenação a sul e outra a norte do país, de forma a uniformizar e transversalizar as melhores práticas na abordagem aos tumores digestivos, nas Unidades de saúde da rede CUF.
É composta por equipas multidisciplinares de especialistas na abordagem aos tumores do digestivo alto e aos tumores hepatobiliopancreáticos.
Os nossos doentes e os seus cuidadores contam com um acompanhamento de grande proximidade, transmitindo confiança e esperança na recuperação da doença.
Ao seu dispor encontrará enfermeiros dedicados que o acompanham passo a passo para que se sinta sempre seguro e informado e uma equipa de gestores oncológicos, que facilitam todo o processo administrativo.
Coordenação:
Unidade de Tumores Gastrointestinais a Sul: António Quintela, Oncologista Médico; Susana Mão-de-ferro, Gastrenterologista; Ana Raimundo, Oncologista Médica e Hugo Pinto Marques, Cirurgião Geral
Unidade de Tumores Gastrointestinais a Norte: Carlos Sottomayor, Oncologista Médico; Emanuel Guerreiro, Cirurgião Geral; Manuela Machado, Oncologista Médica e Luís Lopes, Gastrenterologista
Faça o seu pedido de contacto para o podermos acompanhar desde o primeiro momento.
Se preferir pode agendar uma consulta através da nossa linha gratuita.
As especialidades mais envolvidas no diagnóstico e tratamento dos tumores do digestivo alto são:
- Gastrenterologia
- Cirurgia Geral
- Anatomia Patológica
- Imagiologia
- Medicina Nuclear
- Radioterapia
- Oncologia Médica
Os meios de diagnóstico protocolados para a confirmação dos tumores dos digestivo alto são:
- Endoscopia digestiva alta
- Biópsia gástrica
- Pesquisa de sangue oculto nas fezes
- Exame físico
- Estadiamento tumoral
No caso dos tumores hepatobiliopancreáticos, estão prorocolados os seguintes meios complementares de diagnóstico:
- Análises gerais ao sangue
- Ecografia
- Tomografia Computorizada (TC)
- Ressonância Magnética (RM)
- Endoscopia
- Ecoendoscopia
- Colangiopancreatografía retrógrada endoscópica (CPRE)
- Colangiografia percutânea
- Biopsia hepática
- Biopsia aspirativa percutânea
- Laparoscopia exploradora
- Estadiamento tumoral
O tratamento escolhido irá depender do tipo de tumor e do estado geral do doente.
TUMORES DO DIGESTIVO ALTO
Terapêutica Endoscópica
Cirurgia
- Esofagectomia
- Gastrectomia
- Outras intervenções
Quimioterapia
Radioterapia
TUMORES HEPATOBILIOPANCRÁTICOS
Cancro do Pâncreas
- Pancreatectomia distal
- DPC/Cirurgia de Whipple
- Radioterapia
- Terapêutica Sistémica: terapias dirigidas; imunoterapia
Cancro do Fígado
- Cirurgia: Hepatectomia parcial
- Cirurgia: Hepatectomia total
- Ablação por radiofrequência
- Criocirurgia
- Injeção de etanol na lesão
- Embolização
- Quimioembolização
- Radioterapia
- Terapêutica Sistémica: terapias dirigidas; imunoterapia
Cancro das Vias Biliares
- Cirurgia de intenção radical:
- Remoção da via biliar
- Hepatectomia parcial
- DPC/Cirurgia de Whipple
- Cirurgia paliativa ou técnicas locais endoscópicas:
- Bypass biliar
- Colocação de prótese biliar
- Radioterapia
- Quimioterapia
Serviços Clínicos de Apoio
- Hospital de Dia
- Internamento
- Bloco Operatório
- Cuidados Intensivos
- Cuidados Paliativos
- Atendimento Permanente
- Linha de Apoio 24 horas
- Nutrição
- Onco-psicologia
- Todas as especialidades

Portugal conta com o maior número de mortes por cancro do estômago da União Europeia, e é o 6º país a nível mundial. A taxa de incidência do cancro do esófago tem aumentado em países ocidentais, como consequência do aumento da prevalência dos fatores de risco mais importantes: obesidade e refluxo gastro-esofágico.
Saiba mais sobre os principais tipos de cancro do sistema digestivo alto.
Conheça os sintomas e fatores de risco do cancro do pâncreas, do cancro do fígado e do cancro das vias biliares.





